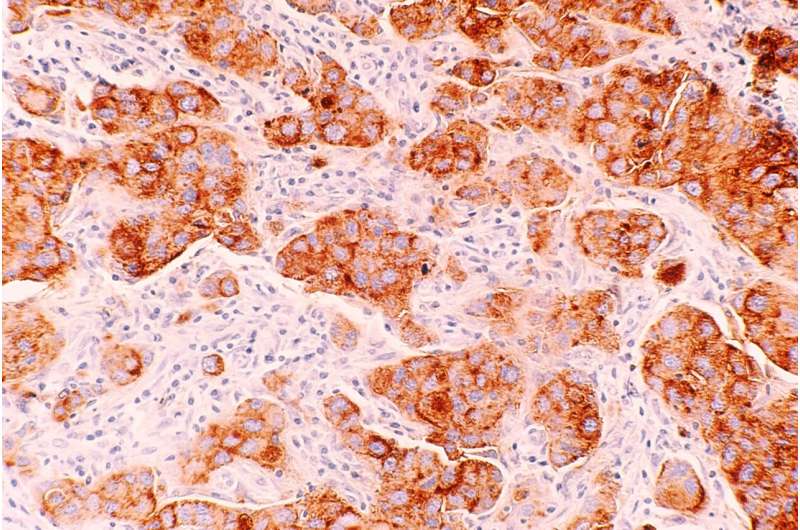
breast cancer cells

-

生物通官微
陪你抓住生命科技
跳动的脉搏
巨噬细胞|侵袭性乳腺癌的关键参与者
【字体: 大 中 小 】 时间:2023年03月20日 来源:Cancer Discovery
大多数旨在增强T细胞活性的免疫疗法在治疗雌激素受体阳性(ER+)乳腺癌时效果不佳。匹兹堡大学医学院科学家领导的一项针对侵袭性ER+乳腺癌的全面新分析表明,靶向一种称为巨噬细胞的不同类型的免疫细胞可能是一种更有效的方法。
今天发表在《Cancer Discovery》杂志上的这项研究发现,巨噬细胞是ER+侵袭性小叶癌(ILC)和侵袭性导管癌(IDC)肿瘤的主要免疫细胞浸润。肿瘤区域的详细空间分析还揭示了与良好患者预后相关的独特免疫细胞“邻居”。
“过去,IDC和ILC被归为一类,并被视为同一种疾病。但在过去的几年里,强有力的证据表明,它们实际上是不同的疾病,”主要作者Sayali Onkar博士说,他目前是西奈山伊坎医学院的高级科学家,他在匹兹堡大学医学院读研究生时进行了这项研究。“我们发现了IDC和ILC在免疫领域的重要相似点和不同点,这表明需要针对性的免疫疗法来针对这些疾病。”
免疫疗法帮助免疫系统更好地识别和摧毁癌细胞。虽然免疫疗法对包括黑素瘤和肺癌在内的许多癌症都有强有力的治疗,但对大多数乳腺癌亚型的效果往往较差――正如Onkar和皮特医学科学家培训项目的学生Neil Carleton最近发表的一篇癌症发现文章所述。
共同资深作者Dario Vignali博士说:“乳腺癌,特别是那些ER+的乳腺癌,对免疫治疗的反应不佳,因此对新疗法的需求巨大。通过测试我们的假设,即IDC和ILC的免疫反应不同,我们可以告诉我们应该在哪些方面关注新方法的开发。”
这项研究得益于Vignali和共同资深作者Steffi Oesterreich博士的合作,Steffi Oesterreich博士是UPMC Hillman癌症生物学项目的联合负责人,匹兹堡大学医学院药理学和化学生物学教授,他们分别在癌症免疫学和乳腺癌生物学方面拥有特殊的专业知识。
通过分析患者样本的肿瘤微环境(肿瘤周围细胞、血管和分子的复杂生态系统),研究人员发现,在ER+ ILC和IDC中,巨噬细胞都是最常见的免疫细胞,但在ILC中尤其突出。
“为了改善这些疾病患者的预后,我们需要确定专注于巨噬细胞的可药物靶点,”Oesterreich说。“巨噬细胞靶向免疫疗法在开发中非常缺乏――绝大多数集中在T细胞上。”
接下来,研究人员利用最先进的技术分析了肿瘤中巨噬细胞、T细胞和其他免疫细胞的空间位置。他们在IDC和ILC肿瘤中发现了独特的细胞“社区”或细胞集群。在IDC研究中,一种以巨噬细胞和CD8+ T细胞为主的邻里与患者无病生存率的增加有关,这表明这些免疫细胞共同作用以杀死癌细胞。
“这些发现告诉我们,缩小观察肿瘤的结构,了解免疫细胞是如何相互影响的,而不是简单地观察细胞的总量,这是很重要的,”Onkar说。“靶向肿瘤微环境中的细胞社区可能对患者的预后产生重大影响。”通过观察居住在肿瘤微环境中的巨噬细胞类型,研究小组发现,与IDC相比,ILC具有更多促进肿瘤的M2样巨噬细胞,而较少抗肿瘤的M1样巨噬细胞。
根据研究人员的说法,这项研究为未来研究开发新的免疫疗法或专注于巨噬细胞的靶标提供了重要的资源。去除有害的M2样巨噬细胞或将其重新编程为M1样巨噬细胞可能是ILC治疗的有前途的途径,更好地了解ER+乳腺癌中巨噬细胞和T细胞之间的伙伴关系可以为这种疾病的联合治疗奠定基础。
由匹兹堡大学提供